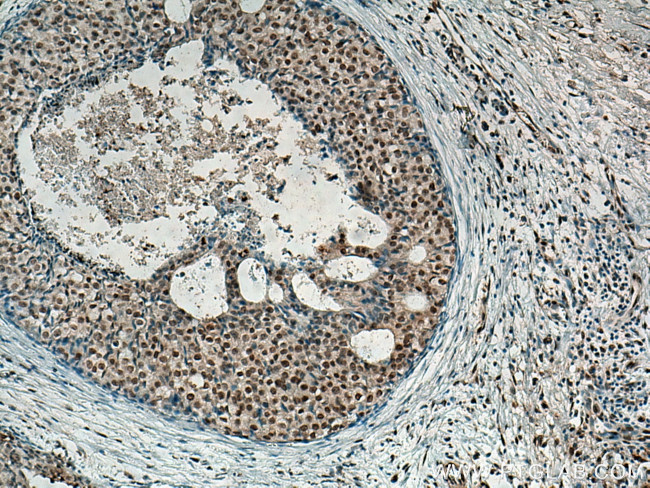
MDM2 Antibody in Immunohistochemistry (Paraffin) (IHC (P))

Search
Proteintech
MDM2 Monoclonal Antibody (2A6C9)
{{$productOrderCtrl.translations['antibody.pdp.commerceCard.promotion.promotions']}}
{{$productOrderCtrl.translations['antibody.pdp.commerceCard.promotion.viewpromo']}}
{{$productOrderCtrl.translations['antibody.pdp.commerceCard.promotion.promocode']}}: {{promo.promoCode}} {{promo.promoTitle}} {{promo.promoDescription}}. {{$productOrderCtrl.translations['antibody.pdp.commerceCard.promotion.learnmore']}}
产品信息
66511-1-IG
种属反应
宿主/亚型
分类
类型
克隆号
抗原
偶联物
形式
浓度
规格
纯化类型
保存液
内含物
保存条件
运输条件
靶标信息
MDM2 is a ubiquitin ligase for p53 and plays a central role in regulation of the stability of p53. MDM2 is located on chromosome 12 on the q arm. Akt-mediated phosphorylation of MDM2 at Ser166 and Ser186 increases its interaction with p300, allowing MDM2-mediated ubiquitination and degradation of p53. Phosphorylation of MDM2 also blocks its binding to p19ARF, increasing the degradation of p53. MDM2 has also been shown to negatively regulate p53 function. MDM2 binds and inhibits transactivation role played by p53 and overexpression of MDM2 can result in the inactivation of p53 and decrease its tumor suppressor function. Another process by which MDM2 can inactivate p53 is by degrading p53 as the protein also possesses E3 ubiquitin ligase activity. Further, MDM2 plays important roles in apoptosis and cell cycle. MDM2 is over expressed in a wide range of human malignancies including soft tissue carcinomas and breast cancer. In addition to p53, MDM2 is involved in processes of cell cycle, apoptosis, and tumorigenesis through interactions with proteins that include retinoblastoma 1 and ribosomal protein L5. More than 40 different alternatively spliced transcript variants of MDM2 have been isolated from both tumor and normal tissues.
仅用于科研。不用于诊断过程。未经明确授权不得转售。
生物信息学
蛋白别名: alternatively spliced isoform; double minute 2; Double minute 2 protein; double minute 2, human homolog of; p53-binding protein; E3 ubiquitin-protein ligase Mdm2; Hdm2; HGNC:6973; human homolog of; MDM2 isoform KB9; MDM2 isoform N1_40; MDM2 oncogene, E3 ubiquitin protein ligase; Mdm2 p53 binding protein homolog; MDM2 proto-oncogene, E3 ubiquitin protein ligase; MDM2 variant FB28; Mdm2, p53 E3 ubiquitin protein ligase homolog; Mdm2, transformed 3T3 cell double minute 2, p53 binding protein; MGC5370; MGC71221; Oncoprotein Mdm2; OTTHUMP00000183490; OTTHUMP00000183492; OTTHUMP00000183494; OTTHUMP00000183495; OTTHUMP00000183496; OTTHUMP00000183497; p53 associated; p53 E3 ubiquitin protein ligase; p53-binding protein Mdm2; RING-type E3 ubiquitin transferase Mdm2; transformed mouse 3T3 cell double minute 2; unnamed protein product
基因别名: 1700007J15Rik; AA415488; ACTFS; hdm2; HDMX; LSKB; Mdm-2; MDM2
UniProt ID: (Human) Q00987, (Mouse) P23804
Entrez Gene ID: (Human) 4193, (Rat) 314856, (Mouse) 17246